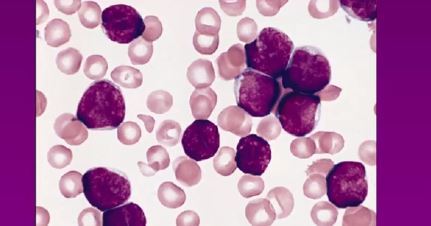

DIAGRAM what is leukemia
series of mutations in myeloid or lymphoid stem cells

difference of leukemia unlike other cancer-
often not any solid tumour- because normal stem cells circulate in blood, these cancer cells circulate in blood
benign vs malignant difference in leukemia
INVASION and METASTASIS don’t apply, so other ways of distinguishing benign and malignant needed: benign= chronic ie goes on for long, and malignant= acute ie disease aggressive
how leukemia classified
chronic vs acute, lymphoid vs myeloid, lymphoid B or T, myeloid megakaryocytic,erythroid,monocytic or granulocytic
causes of leukemia
mutation in protooncogene/TMS, or creation of fusion gene
causes of mutations in leukemia
radiation, anti-cancer drugs, cigarettes, chemicals eg benzene
difference between AML and CML- genes
T.F are affected, so multiple genes affected: in CML, a gene producing protein of membrane receptor or cytoplasmic protein affected, which is not as serious
difference between AML and CML: cells
failure of production of mature cells ie lots of immature cells ie myeloblasts vs too much production of mature cells eg too many granulocytes ie differentiation still occurs
differnce between ACL and CLL- cell
failure of production of mature cells ie lots of immature cells ie lymphoblasts vs mature B/T cells, but still abnormal
features of leukemia due to accumulation of abnormal cells: especially ALL
leucocytosis, bone pain (if acute), hepato/splenomegaly (abnormal cells enter these tissues), lymphadenopathy (ie enlargement of nodes if lymphoid), enlargement of thymus (if T lymphoid), testicular enlargement and skin infiltration
metabolic effects of leukemia
too much uric acid ie renal failure (due to DNA breakdown), weight loss (energy to break down DNA), and fever/sweating (due to high metabolic rate)
effects due to lack of normal cells- especially in ALL and why it occurs in ALL
anemia- leads to fatigue/breathlessness+ pale: thrombocytopenia- leeds to bleeding, bruises+ petechiae: neutropenia= fever: occurs because the amounts of lymphoblasts crowd the other cells
effect of leukemia on immune system, and particularly which type
deficiency due to less B/T cells especially CLL
who does ALL affect most and why
children, due to delayed exposure to common pathogen
DIAGRAM blood film in ALL
very large lymphoblasts
immunophenotyping
tells you were ALL is B or T cell, and whether there’s leukemia- if there is, they will expresss CD19 and TDT
cytogenetic analysis and prognosis
analyses chromosomes, whether there are translocations/extra choromosomes- important of prognosis
FISH in cytogenetic analysis ie fluorescence
if there is translocation, there is fusion of two colours
treatment of ALL
supportive therapy ie gives RBC, platelets and antibiotics- also systemic (as leukemia not one tumour) and intrathecal (via CSF in spine) chemotherapy
types of ALL and effect on treatment
many different types dependent on cytogenetics- effects optimal treatment


